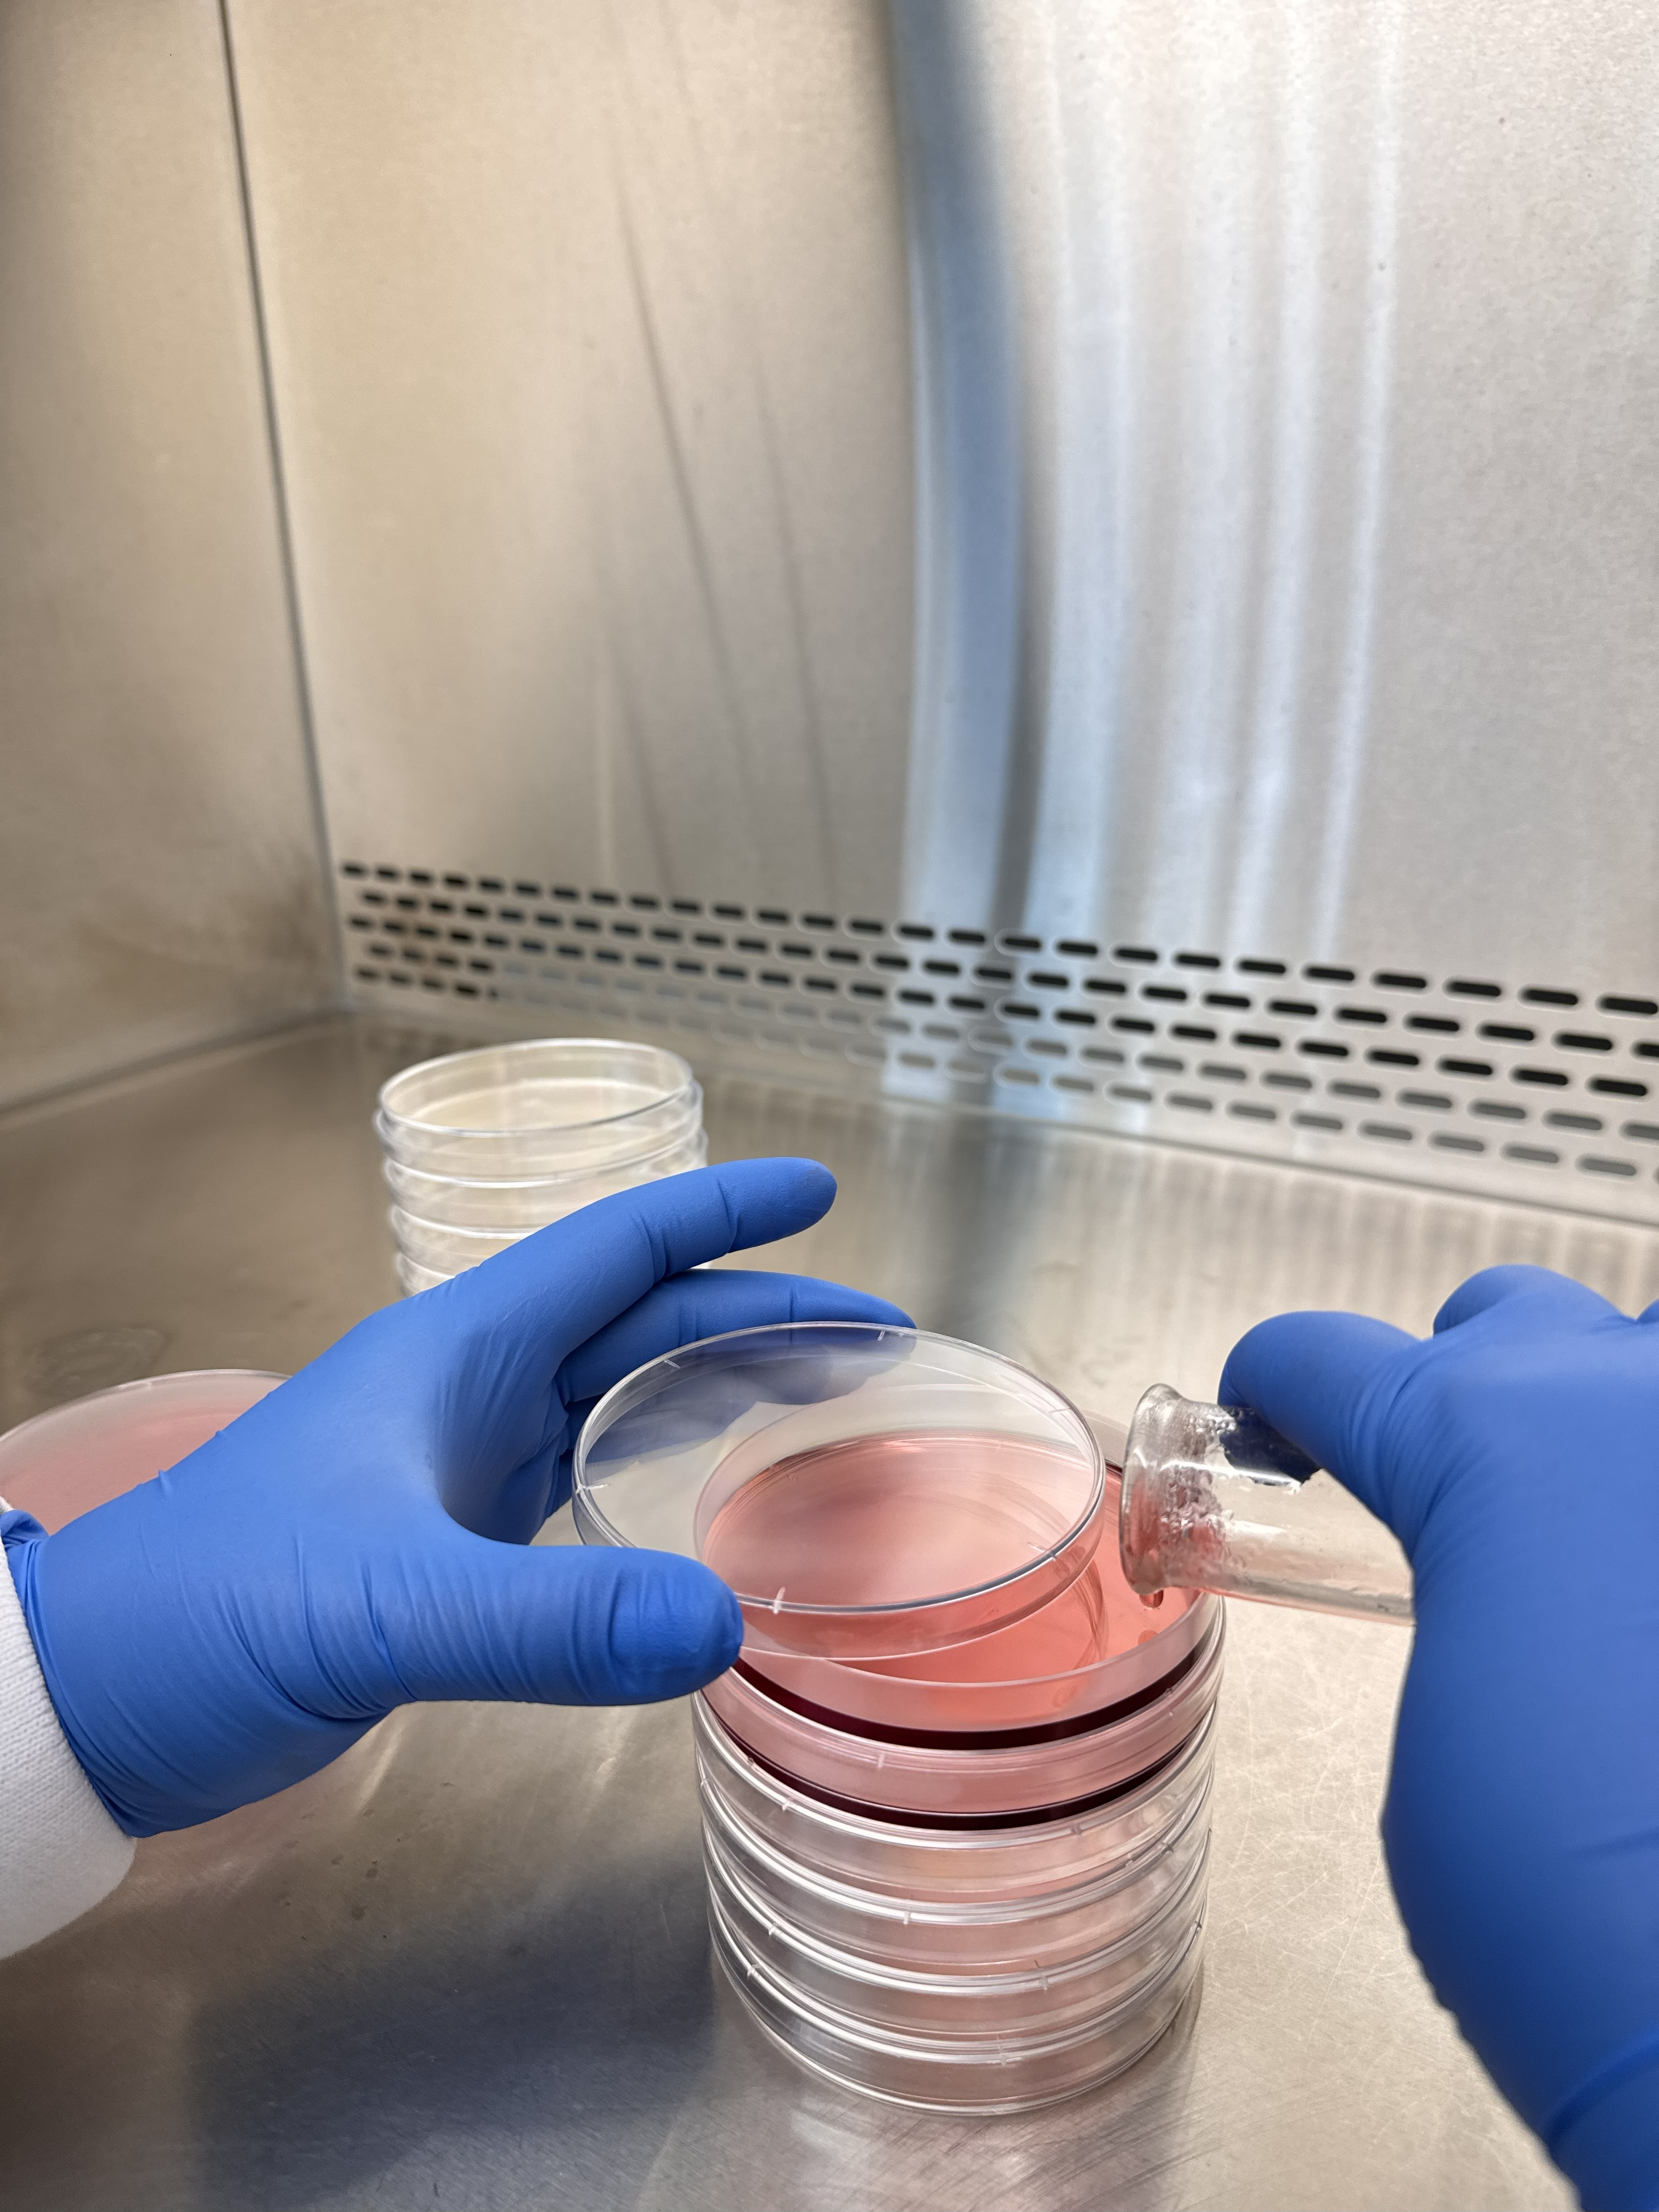

Instalasi Media, Reagensia dan Sterilisasi
Fasilitas ini bertanggung jawab atas tiga fungsi krusial: persiapan media kultur steril, penyiapan larutan reagensia secara akurat, dan sterilisasi peralatan serta dekontaminasi limbah laboratorium. Pengelolaan yang tepat memastikan reproduktifitas hasil penelitian dan menjaga keamanan personel. Instalasi ini merupakan jantung operasional dari Labkesmas yang berfungsi sebagai unit pendukung utama untuk memastikan ketersediaan pasokan steril dan berkualitas tinggi guna menunjang kegiatan diagnostik, pengujian, dan penelitian penyakit menular maupun tidak menular yang berdampak pada kesehatan masyarakat.
Fokus utama dari Instalasi ini adalah Menjadi instalasi sentral yang menjamin ketersediaan media diagnostik, reagensia, dan peralatan steril yang akurat, andal, dan tepat waktu untuk mendukung fungsi surveilans epidemiologi dan respons wabah Labkesmas.
Peran Utama
- Kesiapsiagaan Wabah : Memproduksi media transport virus (VTM) atau media transport bakteri dalam jumlah besar saat terjadi Kejadian Luar Biasa (KLB).
- Surveilans Rutin : Menyediakan media untuk pengujian sampel dari surveilans aktif (misal: kualitas air, keamanan pangan, isolasi Salmonella, E. coli).
- Diagnostik Klinik : Mendukung pemeriksaan spesimen klinis untuk diagnosis TBC, difteri, kolera, dan penyakit infeksi lainnya.
Prosedur Operasional Standar (SOP) Terstandarisasi
SOP di Labkesmas harus selaras dengan pedoman nasional dan internasional.
- SOP Manajemen Batch: Setiap batch produksi harus memiliki nomor lot unik yang tercatat. Dokumentasi mencakup sumber bahan baku, operator, parameter sterilisasi, hasil QC, dan tanggal kadaluwarsa. Sistem Dokumentasi: Menggunakan logbook digital atau LIMS untuk mencatat semua aktivitas, mulai dari penerimaan bahan baku hingga distribusi produk jadi. Ini krusial untuk audit dan akreditasi dan Manajemen Inventaris: Menerapkan sistem First-In, First-Out (FIFO) untuk semua bahan kimia dan media untuk mencegah penggunaan bahan kadaluwarsa.
- SOP Uji Kualitas Media:
- Uji Sterilitas: Wajib untuk setiap batch.
- Uji Fertilitas/Promosi Pertumbuhan : Menggunakan strain mikroba ATCC (American Type Culture Collection) untuk memastikan media dapat menumbuhkan mikroorganisme target.
- Uji Selektivitas/Inhibisi: Memastikan media selektif mampu menghambat pertumbuhan mikroorganisme non-target.
- Uji Sterilitas: Wajib untuk setiap batch.
Pengelolaan Logistik
Sistem logistik kami dirancang untuk menjamin ketersediaan dan kualitas reagen, bahan habis pakai (BHP), dan media, serta integritas sampel (spesimen) dari penerimaan hingga pemusnahan. Kegiatan ini bekerja sama/Koordinasi dengan Instalasi Kalibrasi, Pemeliharaan alat, sarana Prasarana dan Pengelolaan Logistik
- Manajemen Rantai Dingin (Cold Chain):
- Pemantauan suhu berkelanjutan untuk freezer dan kulkas penyimpanan reagen/sampel menggunakan data logger dengan sistem peringatan (alarm) suhu.
- Penggunaan cool box yang tervalidasi dengan ice packs yang memadai untuk transportasi spesimen dan reagen.
- Pemantauan suhu berkelanjutan untuk freezer dan kulkas penyimpanan reagen/sampel menggunakan data logger dengan sistem peringatan (alarm) suhu.
- Proses Utama:
- Perencanaan & Pengadaan: Perencanaan kebutuhan berdasarkan data pemakaian historis dan estimasi kasus, dengan seleksi vendor yang mampu menjamin kualitas dan ketepatan waktu.
- Penerimaan & Penyimpanan: ,
- Setiap reagen dan media yang datang diperiksa tanggal kedaluwarsanya dan kondisi fisiknya.
- Penerapan metode First-Expired, First-Out (FEFO) secara ketat.
- Penyimpanan bahan kimia berbahaya di lemari khusus dengan ventilasi yang baik.
- Setiap reagen dan media yang datang diperiksa tanggal kedaluwarsanya dan kondisi fisiknya.
- Manajemen Spesimen:
- Prosedur penerimaan, pelabelan dengan kode unik, pemrosesan, penyimpanan, hingga pemusnahan spesimen yang jelas dan terdokumentasi untuk menjamin ketertelusuran penuh
- Manajemen Stok:
- Penggunaan sistem kartu stok atau aplikasi manajemen inventaris untuk memonitor level stok dan menentukan titik pemesanan ulang (reorder point).
- Stock opname dilakukan secara periodik untuk memastikan kesesuaian data fisik dan catatan.
- Penggunaan sistem kartu stok atau aplikasi manajemen inventaris untuk memonitor level stok dan menentukan titik pemesanan ulang (reorder point).